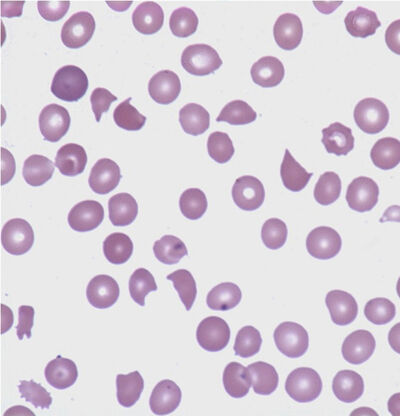

11. tbl. 111. árg. 2025
Umræða og fréttir
Klínísk skoðun og aðferðafræði. Klínísk gagnsemi af smásjárskoðun á blóðstrokum
Skoðun á blóðstroki er mikilvægur þáttur í greiningu blóðsjúkdóma, auk þess sem greina má merki um til dæmis efnaskiptasjúkdóma, næringarskort, bólgusjúkdóma og ýmsar sýkingar út frá blóðstroki. Í síðustu viku kom inn einstaklingur með 200 þúsund hvít blóðkorn og mergbilun en í slíkum tilvikum þarf strax að skoða blóðstrokið, því af því ræðst frekari uppvinnsla og meðferð. Einnig má ekki bíða með smásjárskoðun ef grunur er um alvarlegt bróðrofsblóðleysi (hemolytic anemia).
Í lok 19. aldar voru menn farnir að skoða blóð í smásjá og lita en það var ekki fyrr en 1953 sem Wallace Coulter kom fram með aðferð fyrir sjálfvirka frumuteljara.1 Fyrir þann tíma voru allar mælingar á blóðgildum gerðar í höndum og voru mjög tímafrekar. Frumuteljararnir styðjast við viðnámsmælingar við mat á stærð og talningu fruma og ljósbrotsmælingar fyrir blóðrauða og korn í umfrymi.
Sjálfvirku frumuteljararnir eru hins vegar ekki fullnægjandi til að greina lögun rauðra blóðkorna eins og til dæmis tætlur af rauðum blóðkornum (schistocytar), target-frumur og sigðfrumur en breytingar á lögun rauðra blóðkorna skipta miklu máli fyrir greiningu mismunadi tegunda blóðleysis. Sjálfvirku tækin gefa viðvörun, svokölluð flögg, við ýmsar breytingar á blóðmyndinni eins og aukningu á forstigum kyrningahvítfruma, normóblasta, blasta og reaktívra eitilfruma. Ef þessi flögg koma fram eru gerð blóðstrok fyrir smásjárskoðun. Einnig eru á rannsóknarstofunni ákveðnar vinnureglur fyrir gerð blóðstroka, til dæmis ef heildarfjöldi hvítra blóðkorna er <2,5 eða >30x109/l, Hb<70 eða >180 g/l og blóðflögur <100x109/l og ekki merki um kekkjun eða >1000x109/l.2 Ef þessum skilyrðum er fullnægt eru gerð blóðstrok en í fyrra voru þessar reglur endurskoðar og höfum við fækkað smásjárskoðunum.
Ástæður fyrir smásjárskoðununum koma því í mörgum tilvikum frá rannsóknarstofunni en klínískar ábendingar fyrir smásjárskoðun eru meðal annars óútskýrt blóðleysi, blóðflögufæð og/eða hvítkornafæð. Oft er um að ræða grun um illkynja blóðsjúkdóma og flöggin á frumuteljaranum gefa þar oft sterkar vísbendingar. Smásjárskoðun er einnig mjög mikilvæg ef grunur um blóðrofsblóðleysi (microangiopathic hemolytic anemia, MAHA) eins og til dæmis sega og blóðflögufæðarpurpura (thrombotic thrombocytopenic pupura, TTP) og einnig til að greina dreifða blóðstorknun (disseminated intravascular coagulation, DIC), Miðjarðarhafsblóðleysi (thalassemia), sigðfrumublóðleysi og galla í frumuhimnu rauðra blóðkorna eins og arfgengan hnattrauðkornakvilla (spherocytosis). Einnig er blóðstrok gagnlegt við greiningu á ýmsum arfgengum blóðflögusjúkdómum og sýkingum eins og malaríu og einkyrningssótt.
Í rannsókn sem gerð var í Bandaríkjunum fyrir fimm árum á þremur sjúkrahúsum, tveimur háskólasjúkrahúsum (Emory University Hospital, Atlanta og UMMC, Minneapolis) og einu ríkisreknu sjúkrahúsi (Highland Hospital, Oakland) var athugað hvort niðurstöður af skoðun á blóðstroki hafði klíniskt gildi fyrir meðferð sjúklinganna og hvort smásjárskoðun hefði gefið viðbótarupplýsingar miðað við mælingu á blóðhag.3 Helmingur af smásjárskoðunum var gerður til mats á rauðu blóðmyndinni en í færri tilvikum (24%) var beðið um smásjárskoðun vegna hækkunar eða lækkunar á hvítum blóðkornum. Hins vegar voru meiri líkur á viðbótarupplýsingum við smásjárskoðun vegna brenglunar á hvítum blóðkornum, eða í 25% tilvika samanborið við 19% fyrir rauð blóðkorn og 13% fyrir blóðflögur. Ekki var munur milli stofnana í þessari rannsókn.
Á síðasta ári voru gerðar að meðaltali rúmlega 21.000 mælingar á blóðhag á mánuði hér á Landspítala en það er algengasta rannsóknin sem er gerð á rannsóknarkjarna. Að meðaltali voru gerð 880 blóðstrok/deilitalningar (diff) á mánuði og eru það 4% af heildarfjölda mælinga á blóðhag. Í dag eru blóðstrokin skönnuð í tölvu og gervigreind nýtt til að flokka blóðkornin (CellaVision) en þessi aðferð er ekki alltaf fullnægjandi við mat á rauðu blóðmyndinni og þá er blóðstrokið skoðað í smásjá. Lífeindafræðingar skoða blóðstrokin á tölvuskjánum í samráði við blóðmeinafræðing eftir því sem við á. Einnig er hægt að biðja um álit sérfræðings á blóðstroki og er þá alltaf gert blóðstrok. Oft eru blóðgildin orðin eðlileg þegar beiðni um álit kemur til okkar en gott er að endurtaka blóðhag ef um væg veikindi er að ræða. Eins er hægt að gera skimpróf fyrir sigðfrumublóðleysi sem gefur í raun meiri upplýsingar en blóðstrok þar sem sigðfrumublóðleysi er ennþá sjaldgæft hérlendis.
Í mínu sérnámi í Bandaríkjunum, fyrir allmörgum árum, var lögð áhersla á smásjárskoðun á blóði og merg og hefur mér alltaf fundist sú greiningarvinna mjög skemmtileg. Á vissan hátt má líta á skoðun á blóðstroki sem nauðsynlega kunnáttu fyrir blóðlækninn eins og lungnarannsóknir fyrir lungnalækninn og hjartaómskoðun fyrir hjartalækninn. Þessi þekking er þó víða á undanhaldi en í Bandaríkjunum er ennþá ætlast til að blóðlæknar hafi kunnáttu til að meta blóðstrok.4
Ég tel að í framtíðinni verði ennþá þörf fyrir smásjárskoðun á bóðstrokum en þó er líklegt að aukin sjálfvirkni muni einfalda greiningarvinnuna. Frumuflæðisgreining (FlowDiff) á perifer-blóði í tengslum við sjálfvirku frumuteljarana er fljótleg aðferð1 til að greina nánar hvítu blóðkornin en hjálpar ekki við mat á rauðu blóðmyndinni. Við FlowDiff eru notuð átta mótefni og hefur verið sýnt fram á gott samræmi við hefðbundna smásjárskoðun.5 Hér á Landspítala er alltaf gefið upp véladiff nema tækið flaggi brenglunum á blóðmynd og þá er gert blóðstrok, eins og komið hefur fram hér á undan, og er það gert eftir ákveðnum reglum. Þegar beðið er um álit sérfræðings á blóðstroki er mikilvægt að hafa í huga hver vandamálin eru, ef vægar breytingar eru á blóðmynd, er ekki líklegt að blóðstokið sé gagnlegt. Ef um er að ræða langvarandi breytingar eða skyndilega breytingu og grunur er um illkynja blóðsjúkdóm eða alvarlegt blóðrofsblóðleysi, þarf hins vegar að skoða blóðstrokið strax.
Mynd 1. Rauðblóðkornatætlur (schistocytar) við blóðrofsblóðleysi. (Mynd/ASH Image Bank)

Mynd 2. Bráða mergfrumu hvítblæði. (Mynd: Ash Image Bank)
